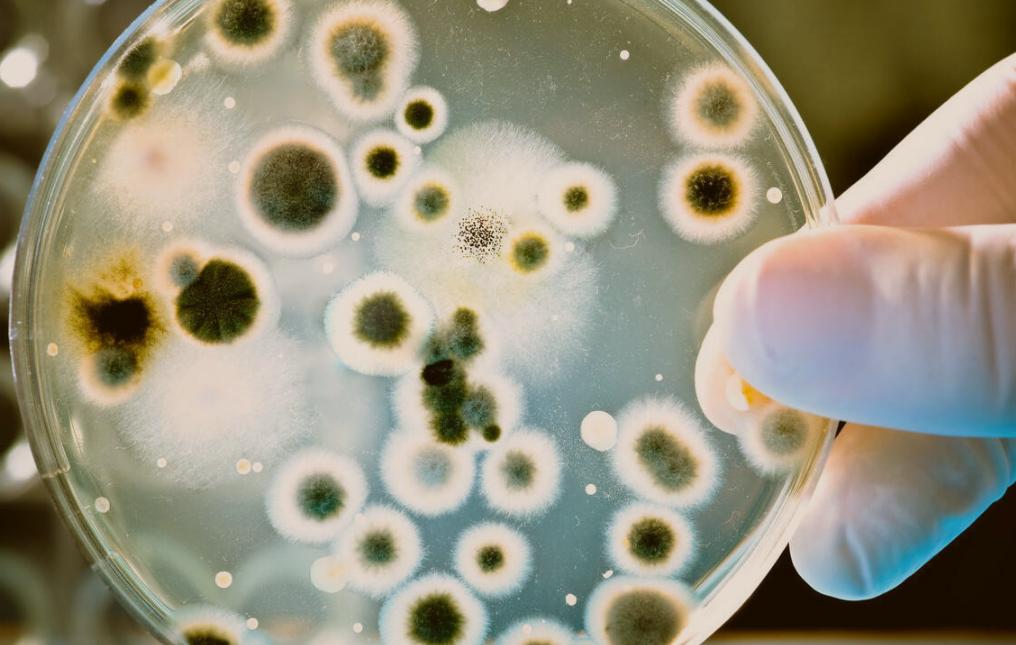
外阴总是很干怎么回事,外阴老是干是怎么回事

阴道是女性非常重要的器官,它连接着子宫,精子就是以阴道为起点游向子宫与卵子结合生成受精卵,从而诞生新生命。
阴道的表面覆盖着复层鳞状上皮,所以阴道内部是褶皱状,富有延展性,是胎儿出生时产道的一部分。
平时阴道是前壁贴合着后壁保持关闭状态,只有在*生活性**、婴儿分娩、月经期时才会展开。
同时阴道也是夫妻之间*生活性**的主要位置,女性在足够的性刺激下会分泌透明的“爱液”来给*生活性**润滑。
但是随着年龄的增加,不少女性朋友会发现自己阴道如同旱季的河流一样变得越来越干涸,这是什么原因造成的呢?又有哪些方法可以保持阴道的健康呢?

一、阴道干,可能跟这些原因有关,别再忽视 !
阴道如果变得干涩会给*生活性**带来一些麻烦,对没有使用润滑液习惯的夫妻就会更容易导致*生活性**不和谐,*交性**时会有疼痛、性快感减退,时间久了甚至会出现性冷淡的情况,夫妻之间和谐的情感也会受到影响。
而之所以女性阴道变得干涩,很有可能跟年龄增长相关。
女性一旦过了40岁,尤其是在围绝经期前后,卵巢的功能会出现衰退的现象,体内的雌激素水平自然也会下降,激素减少会导致前庭大腺分泌液体减少,而前庭大腺液恰恰就是组成阴道分泌液体的重要组成部分。
除了激素减少带来的阴道干涩,另一个相当重要的原因就是炎症。

阴道部位的炎症最常见的自然就是阴道炎,由于阴道是可以与外界直接接触的器官,所以阴道很容易受到外界细菌的感染,产生炎症。
而炎症会导致阴道内壁黏膜水肿增生,使得阴道内的菌群失调,就会导致阴道腺体分泌减少,从而出现阴道没水的现象,同时可能还伴有阴道疼痛的问题。
除此之外,女性的一个生活习惯也是导致阴道干涩的重要元凶之一,那就是过度清洁阴道。
阴道里面是有一个自己稳定的,相对封闭的系统,对于健康女性来说,日常的阴道清洁使用清水就足够了。但是很多人觉得用清水清洁力不够,会选择用广告上的各种阴道清洁剂来清洁阴道。

但是大家想一下,这种清洁剂本身是针对那些有妇科疾病的女性设计的,所以健康的女性用不仅不会达到自己想要的深度清洁效果,反而会导致阴道本身内部的菌群紊乱,造成免疫漏洞,引发各种炎症,阴道的分泌物自然也会减少。
那我们日常应该如何保持阴道的健康呢?有什么小秘密吗?
二、保持阴道健康,这些小秘密,你可能还不知道
1、阴道里住着什么细菌,它们又有什么作用?
很多人认为健康的环境就是无菌的环境,但是这种想法是错误的。
细菌对人体来说并不都是坏的,很多细菌在身体中都发挥着重要的作用。

我们的肠道中住着许多有助于食物消化吸收的细菌,如果没有它,人类对于营养物质的消化吸收效率将大打折扣。
阴道里面也住着一群对健康有益的乳酸杆菌,这些乳酸杆菌是由于可以发酵糖分而产生乳酸而得名,这个乳酸杆菌在女性的阴道中是非常重要的“健康卫士”。
乳杆菌分泌糖分产生乳酸协调雌激素的作用,可以使阴道的pH维持在3.8到4.4之间,要知道,人体内部的pH值可是维持在7.35至7.45之间,相比于人体内环境,阴道的环境可以说是非常“酸”了。
这个酸性环境对于细菌来说是很难生存繁殖的,所以可以维持阴道内部的环境稳定。

乳酸杆菌除了维持阴道的酸性环境之外,还可以抑制其他病原微生物的生长。
乳酸杆菌可以住在阴道里面,那么肯定其他的细菌也想住这里,其中不乏一些会致病的微生物。
但是不用担心,乳酸杆菌可以分泌过氧化氢、细菌素和其他抗微生物因子来抑制或杀灭致病微生物,同时通过细菌之间的竞争排斥机制,可以阻止各种致病微生物粘附于阴道上皮细胞,从而维持阴道的微生态平衡。
2、听说多喝酸奶可以补充阴道乳酸杆菌?
很多人都认为大家日常生活中所遇到的乳酸杆菌都是用来发酵酸奶的,那多喝酸奶是不是也可以多补充阴道中辛苦工作的乳酸杆菌呢?
要知道大家现在经常喝的酸奶中常见的益生菌,包括嗜酸乳酸杆菌,双歧杆菌等,这些菌类有调整肠道菌群平衡,抑制肠道不良微生物异常增殖的作用。

乳杆菌属如果细分的话可以分为卷曲乳酸杆菌、詹氏乳酸杆菌、加氏乳酸杆菌、惰性乳酸杆菌、阴道乳酸杆菌、干酪乳酸杆菌等。
女性阴道内的益生菌则为阴道乳酸杆菌。大家可以直接从名字上看出来,它们各自是有很大区别的。
我们直接喝酸奶,相比于阴道受益更大的是肠道。
阴道的乳杆菌平衡主要是靠人体自身的调节,喝酸奶所补充的乳杆菌与阴道所需要的乳杆菌并不是同一种,可以说是驴唇不对马嘴,所以喝酸奶对阴道的微生物环境并没有什么影响!
3、那是不是乳酸杆菌生长的越多对健康越好呢?
有一句话叫“水满则溢,月盈则亏”,过犹不及这个道理对于阴道内的乳酸杆菌来说自然也是一样。
阴道内的乳酸杆菌如果过度生长,就会分泌过量的乳酸,从而造成阴道复层鳞状上皮细胞溶解破裂进而引发一种名为细胞溶解性阴道病(Cytolytic Vaginosis,CV)的疾病。
而细胞溶解性阴道病的症状与外阴阴道假丝酵母菌病(VVC)十分类似,并没有什么特异的临床表现,最常见的表现就是外阴瘙痒,同时伴有外阴及阴道灼烧痛,阴道分泌物异味、排尿困难以及*交性**痛,阴道分泌物常为白色的豆渣样物质。
所以阴道里面的乳酸杆菌无论过多还是过少都不太好,我们想要保持卫生来维护健康,并不需要乱七八糟的各种洗涤液,只要用清水清洁外阴就足够了,不然会破坏阴道的菌群生态平衡,引发疾病。

4、阴道在性刺激下会变长?
在没有受到刺激的正常情况下,女性的阴道长度大概在8.5厘米到12厘米之间,看起来似乎不太长,跟某些男性的阴茎长度比起来,似乎是不太能匹配。
但实际上女性在受到性刺激后,阴道会发生长度的变化,它的长度可以增加到原来的两倍,如果在*生活性**的时候配合合适的前戏,能够进一步扩长阴道,在阴道增长的同时宽度也会迅速缩小,以达到与男性阴茎亲密接触的目的,从而使夫妻之间的*生活性**变得和谐快乐。
5、不是所有的阴道都有处女膜
这是一个流传了很多年的谣言,民间传言处女膜可以证明女性是不是处女。

其实,处女膜还有另外的名字叫做尿道瓣,处女膜并不是长在阴道里面的,而是在阴道开口处,并不是一个完整的膜,而是有开口的,女性的月经和白带会从这里流出来。
如果没有开口的被称之为处女膜闭锁,这是一种疾病,如果没有及时发现的话,会阻碍经血的流出导致阴道积血,需要手术切开治疗。
而导致流言传播的所谓“*夜初**落红”,则完全是因为双方性知识不足,在第一次接触时没有充分做好前戏来扩张阴道,导致的处女膜撕裂出血,天生没有处女膜的女性就不会有这种情况。

三、那阴道反复干涩?该怎么办?
治病的时候大家都讲究的一个对症下药,首先大家要分清楚自己究竟是因为什么原因才导致的阴道反复干涩,如果仅仅只是生理性的分泌减少,那可以在*生活性**的时候常备一瓶润滑剂在床头,来润滑阴道,减少不舒适的干涩感,保证*生活性**的质量。
如果是因为激素减少,可以选择适当补充雌孕激素。在医生的指导下服用乙烯雌酚、炔诺酮;也可在阴道放置外用乙烯雌酚,外用药物要间歇使用,每次用3-5天,具体疗法一定要根据疗效咨询医生。

很多医生会推荐阴道干涩的女性患者吃维生素B2,用它来缓解干涩情况。
这是因为,维生素B2能够通过参与脂肪与蛋白质的代谢促进细胞的发育和再生,提高机体对蛋白质的利用率,使表皮细胞新陈代谢的速度加快,维护皮肤和组织的完整性。
但是维生素B2在我们体内的存储量是有限的,只能通过日常饮食补充,如果缺乏维生素B2会使人体粘膜变薄、粘膜层容易损伤、微血管破裂。
阴道就是一个非常典型的黏膜环境,所以我们可以选择维生素B2来促进阴道粘膜的修复和细胞的新陈代谢,以达到缓解阴道干涩的目的。
而且相比于雌激素,维生素B2的适用范围更广,更有普适性。而医生推荐的阴道干涩患者使用方法是每天2~3次,每次2片。

如果是因为感染导致的阴道干涩,应该及时到医院进行检查,根据病原体的不同选择合适的药物,常见的滴虫性阴道炎一般用抗厌氧菌药,而另一种常见的霉菌性阴道炎则要使用抗真菌药,解决病因才能从根本上改善阴道干涩。
若是阴道炎症导致的阴道干涩,则需要通过白带的化验分析选择合适的药物。
参考文献:
[1]廖芝,靳军,程光辉等.中药联合莉芙敏片治疗中老年女性阴道干涩(肝肾阴虚证)的临床研究[J].中国医学创新,2023,20(16):91-94.
[2]陈洁,史迅,李享等.绝经后女性*生活性**体验的质性研究[J].生殖医学杂志,2023,32(01):61-67.
[3]李军,刘宇.同房时,阴道干涩怎么破[J].大众健康,2021(09):108.